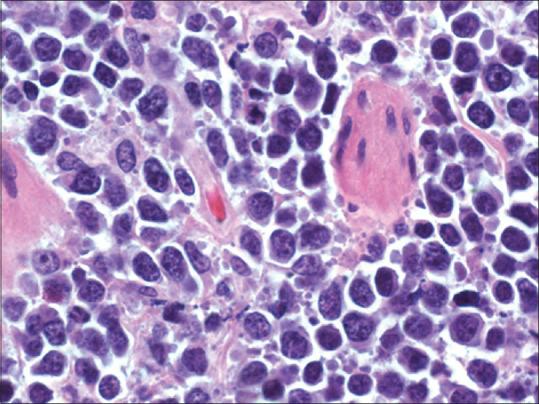

通过F-氟脱氧葡萄糖正电子发射断层扫描检测到的胆囊淋巴瘤。
Gallbladder lymphoma detected by F-fluorodeoxyglucose positron emission tomography.
作者信息
So Alvin, Sheldon James, Kua Hock
机构信息
Monash Imaging, Monash Health, Victoria, 3168, Australia.
Monash Pathology, Monash Health, Clayton, Victoria, 3168, Australia.
出版信息
World J Nucl Med. 2020 Sep 14;19(4):428-431. doi: 10.4103/wjnm.WJNM_19_20. eCollection 2020 Oct-Dec.
Gallbladder involvement in lymphoma is rare, with only a few cases reported in the literature, predominately in the pre positron emission tomography (PET) era. F-fluorodeoxyglucose (F-FDG) PET/computed tomography (CT) has now become the modality of choice in the staging of lymphoma. We report a case of gallbladder involvement by high-grade B-cell lymphoma detected by PET/CT.
胆囊受累于淋巴瘤较为罕见,文献中仅报道过少数病例,主要是在正电子发射断层扫描(PET)应用之前的时代。氟代脱氧葡萄糖(F-FDG)PET/计算机断层扫描(CT)现已成为淋巴瘤分期的首选检查方式。我们报告一例通过PET/CT检测出的高级别B细胞淋巴瘤累及胆囊的病例。